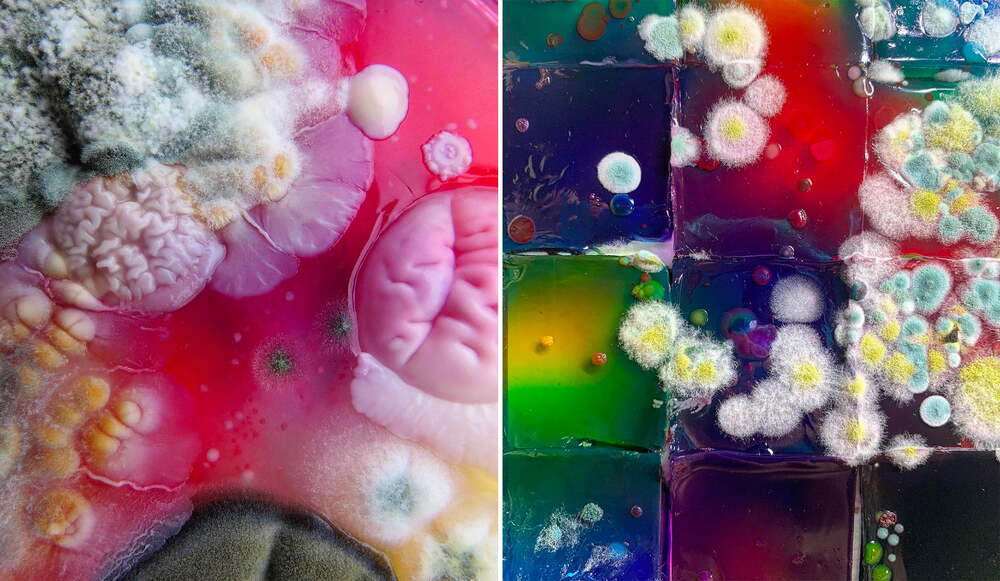

Bakterilerle, küflerle, yosunla ve mantarla yapılan yaratıcı işler hem sanat hem de tasarım dünyasında sıklıkla karşımıza çıkıyor. Yosun ve mantarla yapılan portreler, bakterilerle çizilen Game of Thrones mühürleri, New York’taki mikroskobik yaşamı ele alan fotoğraflar aklımıza kazınan örneklerdendi. Yine bakterilerle dokunan ayakkabı ve güneş gördükçe görünür olan yosun bazlı mürekkep de dikkat çekici örnekler arasındaydı. Şimdi de küflerle yaratılan eşsiz eserler var karşımızda.
Petri kaplarındaki rengarenk koloniler
Bu eserlerin yaratıcısı, Moskova merkezli sanatçı Daria Fedorova. Kendisi, dijital dünyada Dasha Plesen ismiyle tanınıyor. Sanatçı, biyologların kullandığı petri kapları (kültür kapları), küf mantarları ve bakterilerle çalışıyor. Küflerin doğal büyüme süreçlerine doku ve renk açısından müdahale ederek nefis kompozisyonlar yaratıyor.

Sanatçı; küçük toplar, şekerlemeler ve renkli granül şekerler gibi ekstra malzemeleri yerleştirmeden önce petri kaplarını çeşitli bakteri ve diğer mikroorganizmalarla dolduruyor. Eklediği nesneler bakteri ve mantarların büyüme süreçlerini etkiliyor. Böylece pastel tonlarındaki küflerle zıtlık teşkil eden canlı renklerde ve sıra dışı dokularda koloniler ortaya çıkıyor. Kompozisyonların son halini alması üç ila dört hafta sürüyor.
Plesen projenin “çevremizin mikrobiyolojik haritasını çıkarma fikri” ile başladığını belirtiyor. Hepimizin sporlar ve mikroorganizmalar okyanusunda yüzdüğümüze, onları soluduğumuza derimizin üstünde ve vücudumuzun içinde taşıdığımıza dikkat çekiyor. Bu mikro dünya, görebildiğimiz ve dokunabildiğimiz fiziksel dünya ile bir başka dünya arasında duruyor. Bu, metafizik gibi görünmez olan başka bir fiziksel dünya. Sanatçı bu görünmeyen mikro dünya ile görünür olan arasındaki paralelliklerle ilgileniyor.
Sonuçta ortaya çıkan çalışmalar; insan müdahalesi, yapay döngüsel süreçler ve çürümenin doğal güzelliği hakkında sorularla dolu. Plesen’in eserlerinden oluşan daha geniş bir koleksiyonu, sanatçının Behance ve Instagram profili üzerinden görebilirsiniz.

Görsel: Behance






